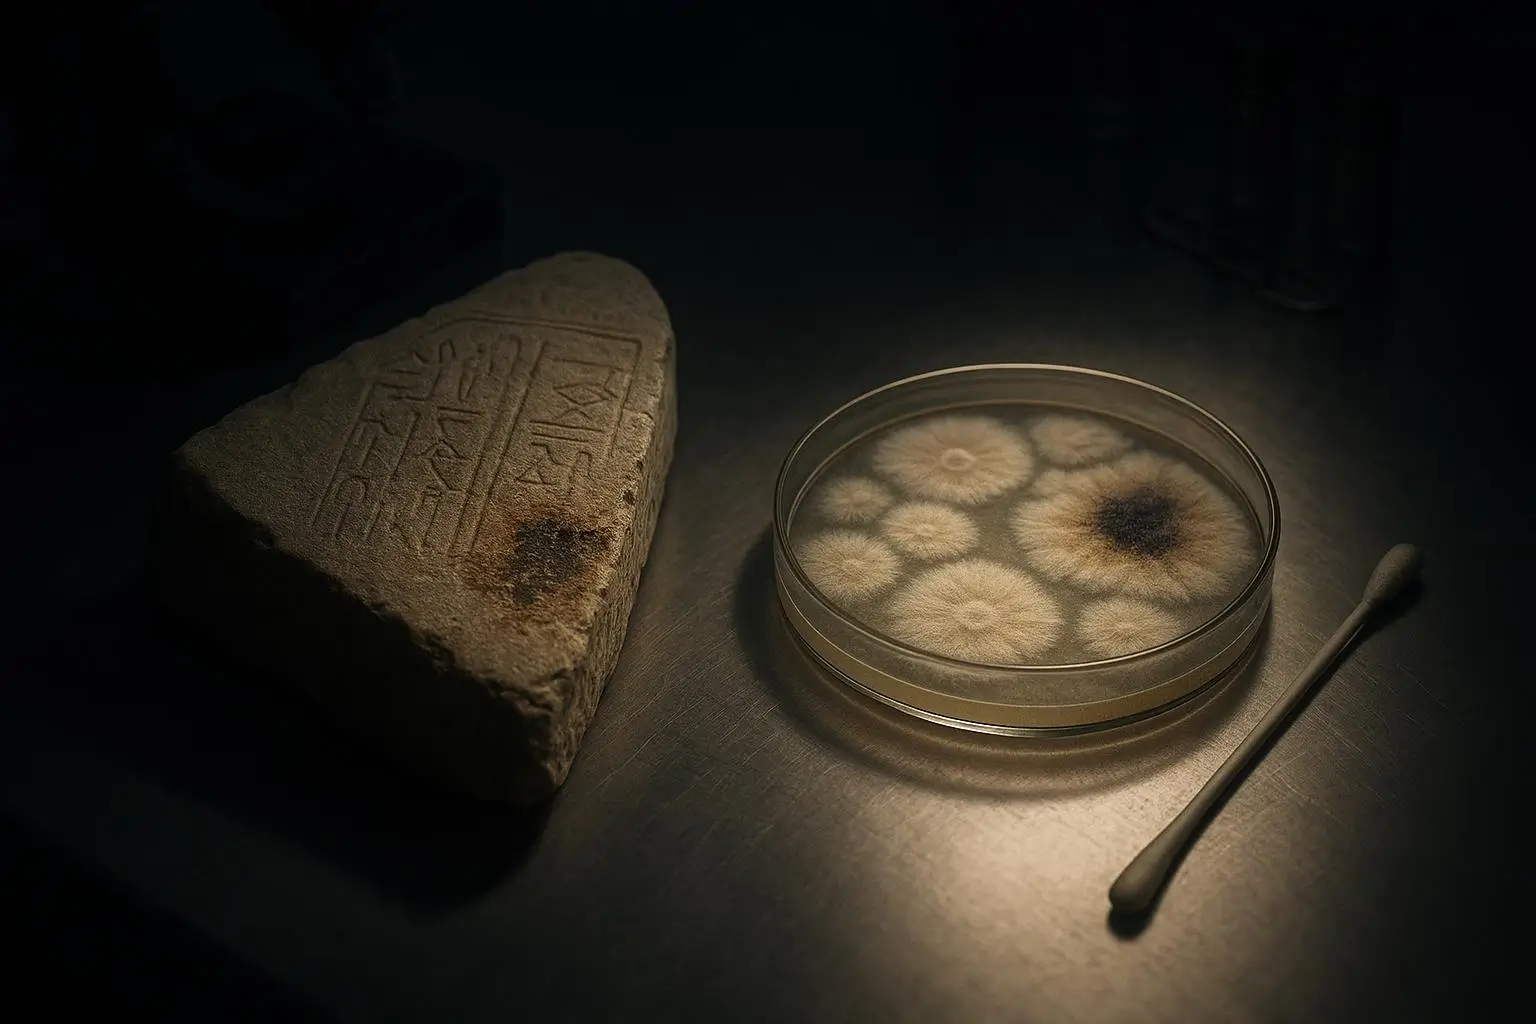
Momias Malditas Fragmento De Piedra Y Placa Circular Iluminados Superficie metálica con momias malditas, fragmento de piedra grabada, placa circular transparente y hisopo

Momias malditas: del mito de Tutankamón a los datos del archivo
Imagina la escena: una pantalla abierta en la entrada de «Curse of the pharaohs» en Wikipedia, el párrafo subrayado donde se lee que en la tumba de Tutankamón no hay ninguna inscripción de amenaza. Piensas en la arena levantándose en 1922, en Howard Carter encendiendo una vela, en Lord Carnarvon mirando por encima del hombro, y en la palabra «maldición» flotando en los titulares. Llegas casi esperando leer la frase grabada en la piedra, esa advertencia letal que la cultura popular ha repetido hasta el agotamiento. Pero si la famosa frase nunca estuvo en los muros, ¿de dónde sale la idea de unas momias malditas capaces de matar a todo el que entra en la tumba? Ahí empieza el rastro documental, y ahí es donde el mito se encuentra con el archivo.
Lo que dicen realmente tumbas y papeles
El mapa mínimo arranca en 1922. La entrada de Wikipedia sobre el hallazgo de KV62 ordena la cronología: excavación en el Valle de los Reyes, patronazgo de Carnarvon, apertura gradual de cámaras y un interés mediático que crecía con cada titular. Si te interesan otros misterios de la arqueología, este caso es un punto de partida excelente.[1]
Vuelves a la pestaña de «Curse of the pharaohs» y la fricción aparece de golpe: la tumba de Tutankamón no contiene ninguna inscripción de maldición. Lo escrito es claro; lo ausente, más. Buscas la frase que todo el mundo cita y descubres que no está en ninguna parte del registro arqueológico.[2]
Otro documento digital abre una ventana distinta: la página de National Museums Scotland muestra advertencias funerarias egipcias auténticas. No hablan de rayos mortales ni de venganzas sobrenaturales, sino de violaciones de tumbas, de ofensas a los dioses, con un tono casi jurídico que suena más a contrato que a condena.[3]
Aquí falta algo que esperabas encontrar. La cultura popular ha fijado una frase precisa para Tutankamón que ningún muro recoge. El archivo establece un mínimo: hay maldiciones en otras tumbas egipcias, hay una tumba famosa sin maldición escrita y, sin embargo, el mito se pegó a ella con una fuerza que ningún jeroglífico explica. Da la impresión de que la maldición de Tutankamón se escribió más en las redacciones de los periódicos que en las paredes de la cámara funeraria.

De muerte clínica a castigo faraónico
La siguiente pestaña muestra un artículo en History Today. Ahí, titulares de hace un siglo convierten la muerte de Carnarvon en castigo ejemplar. La escena de prensa es casi un guion: conde millonario, tumba recién abierta, fallecimiento poco después. El relato funciona tan bien que casi no necesita datos.[4]
El historial médico, sin embargo, es concreto: una picadura de mosquito, un corte al afeitarse, infección cutánea, luego septicemia. Te sorprende comprobar que, una vez pasas de los titulares a los partes médicos, las muertes suenan mucho menos a castigo divino. El archivo muestra una cadena clínica convencional; el relato la recorta en «entró en la tumba y murió», y esa versión resulta infinitamente más memorable. El tema conecta directamente con los misterios del antiguo egipto que tanto fascinan a investigadores y curiosos.
Un segundo artículo, esta vez en History Answers, compila crónicas de apagones, perros que mueren al mismo tiempo y frases espiritistas. El propio texto los presenta como ejemplos tempranos de noticias sin verificar alrededor de la tumba. Mientras lees las anécdotas, notas cómo tu cerebro disfruta del relato, incluso cuando el texto te recuerda que no hay forma de contrastarlas bien.[5]
En el Club, seguimos lo que queda escrito, no lo que se imagina. Y lo escrito distingue mal entre testimonio contrastable y anécdota perfecta para alimentar el mito de la maldición de los faraones. El atractivo narrativo del faraón vengativo pesó más en los titulares que cualquier diagnóstico clínico concreto.
History Answers también repasa otros nombres: personas vinculadas a la excavación o al entorno de Howard Carter que murieron años después, por causas muy diversas. La estructura de la lista existe, pero el detalle no llega: los nombres mezclan presentes en la tumba, visitantes ocasionales y figuras tangenciales. Juntas, esas cifras dibujan un patrón reconocible para quien quiere verlo, pero difuso cuando intentas trazarlo con rigor.
Estadísticas, hongos y límites de lectura
La fricción sube cuando miras los números. Abres el artículo del BMJ en la base de datos de los NIH: una tabla compara la supervivencia de personas «expuestas» a la tumba con un grupo de control. No hay diferencia significativa en esperanza de vida. Cuando ves la tabla, quizá te descubras buscando desesperadamente alguna columna que salve la maldición, y no la encuentras.[6]
En paralelo, otro PDF científico de PMC estudia colonias de hongos en un monumento calcáreo egipcio. El gráfico esquemático relaciona Aspergillus en piedra funeraria con riesgo de aspergilosis en espacios cerrados.[7]
Aquí el cerebro busca atajos: si hay hongos peligrosos en tumbas egipcias y hubo muertes tras la apertura de KV62, ¿las momias malditas escondían en realidad esporas letales? Es posible que una parte de ti quiera que los hongos cierren la historia de forma elegante, como explicación oculta, pero el propio expediente te obliga a frenar. El archivo parcial sobre la tumba de Tutankamón no permite afirmarlo. Los estudios muestran riesgo biológico plausible en contextos parecidos, pero la documentación limitada para la tumba concreta impide trazar una línea directa entre esporas y nombres.
Además, el BMJ introduce un contrapunto duro: aunque imagináramos un agente nocivo en el aire de la tumba, la serie fragmentada de fallecimientos, dispersa en años y causas clínicas, no encaja con un patrón tóxico uniforme. Las validaciones no concluyentes de hipótesis fúngicas para Tutankamón son parte de la honestidad del expediente. Con lo que sobrevive, la historia se aclara, pero no se cierra. Te quedas con la sensación extraña de que la explicación más cómoda emocionalmente es justo la que peor aguanta el contraste con las cifras.
Del «hongo maldito» al potencial fármaco
La última capa te devuelve al navegador. En una pestaña, el blog de la Escuela de Ingeniería de la Universidad de Pensilvania cuenta cómo investigadores han aislado asperigimycinas a partir de Aspergillus flavus para explorarlas como tratamiento antileucémico. El giro del «hongo maldito» a posible fármaco anticáncer resume bien cómo un mismo organismo puede pasar de monstruo cultural a recurso biomédico.[8]
En otra pestaña, un artículo de divulgación en Live Science enlaza ese mismo hongo con la vieja historia de la tumba de Tutankamón, explicando la hipótesis de los hongos de forma prudente y subrayando la ausencia de pruebas directas en KV62.[9]
La fricción final es doble. Por un lado, aceptas que hay riesgos reales en criptas: polvo, esporas, infecciones en personas vulnerables. Por otro, ves que el mismo organismo usado como gancho para noticias sobre momias malditas puede convertirse en herramienta contra el cáncer. La hipótesis de hongos peligrosos funciona como recordatorio de que las criptas encierran riesgos reales, aunque en KV62 falten datos directos para cerrar el círculo. Si quieres ampliar tu perspectiva sobre grandes enigmas similares, puedes explorar los misterios de las piramides giza.
Relees entonces la síntesis divulgativa en JSTOR Daily sobre el estudio del BMJ: el diseño de cohorte, las curvas de supervivencia, la conclusión seca de que la tumba no acortó vidas de forma demostrable. Leyendo las tablas de supervivencia, cuesta sostener la idea de una maldición que acorte vidas más de lo esperable.[10]
La pregunta del inicio —si había algo letal más allá del polvo— recibe una respuesta matizada. Los documentos arqueológicos muestran una tumba sin frase de amenaza. Los registros médicos hablan de septicemia, cáncer, infecciones comunes. El análisis estadístico no detecta una maldición que mate más de lo esperable. Lo que queda abierto es el detalle microbiológico: no sabemos qué había exactamente en el aire de KV62 ni cómo afectó, si lo hizo, a individuos concretos. Ese hueco pertenece más a la microbiología fina que al castigo sobrenatural.
Lo que sí muestra el conjunto es otra cosa: el castigo sobrenatural funciona mejor como historia que cualquier tabla de supervivencia. Entre momias egipcias, hongos y titulares, el archivo fija un mínimo sólido y deja fuera del perímetro documental lo que pertenece al terreno del relato. Sales del recorrido sabiendo hasta dónde llegan los papeles y notando cuánto rellena la imaginación cuando el archivo se queda corto. La próxima vez que alguien cite una «maldición de momias malditas», sabrás qué puede afirmarse con rigor —y dónde empieza la necesidad humana de que un faraón haga justicia desde la tumba.
Preguntas frecuentes
¿Existía una inscripción de maldición en la tumba de Tutankamón?
No. Los registros arqueológicos indican que en KV62 no se halló ninguna frase de advertencia letal, a diferencia de otras tumbas egipcias con textos protectores. Fuente: Wikipedia, artículo enciclopédico, wikipedia.org
¿La muerte de Lord Carnarvon prueba la maldición de los faraones?
No. Los informes contemporáneos describen una infección cutánea tras una picadura de mosquito y un corte al afeitarse, que derivó en septicemia, un cuadro clínico conocido. Fuente: History Today, artículo histórico, historytoday.com
¿Los estudios estadísticos apoyan la existencia de una maldición de Tutankamón?
Un estudio de cohorte publicado en BMJ comparó la supervivencia de personas expuestas y no expuestas a la tumba y no halló exceso de mortalidad. Fuente: BMJ vía National Library of Medicine, artículo científico, ncbi.nlm.nih.gov
¿Los hongos en tumbas egipcias pueden ser peligrosos?
Sí, algunos hongos como Aspergillus pueden causar infecciones respiratorias graves en personas vulnerables, aunque no se ha demostrado un vínculo directo con KV62. Fuente: Journal of Fungi vía National Library of Medicine, artículo científico, ncbi.nlm.nih.gov
¿Es cierto que el «hongo de la maldición» se estudia como fármaco?
Investigaciones recientes exploran compuestos derivados de Aspergillus flavus, llamados asperigimycinas, como posibles tratamientos contra ciertos tipos de leucemia. Fuente: University of Pennsylvania, blog institucional, seas.upenn.edu
Los documentos se cierran, las preguntas no.
En el Club Curioso probamos lo improbable con método. Archivamos los hechos, comparamos lecturas y dejamos margen a los datos.
Si has llegado hasta aquí, ya compartes la paciencia del archivo.
Fuentes consultadas
- Wikipedia, recurso en línea, en.wikipedia.org, consulta 2025-10-03
- Wikipedia, recurso en línea, en.wikipedia.org, consulta 2025-09-28
- National Museums Scotland, recurso en línea, nms.ac.uk, consulta 2025-10-11
- History Today, recurso en línea, historytoday.com, consulta 2025-09-19
- History Answers, recurso en línea, historyanswers.co.uk, consulta 2025-10-22
- BMJ vía PMC, recurso en línea, pmc.ncbi.nlm.nih.gov, consulta 2025-11-05
- Journal of Fungi vía PMC, recurso en línea, pmc.ncbi.nlm.nih.gov, consulta 2025-10-15
- University of Pennsylvania, recurso en línea, blog.seas.upenn.edu, consulta 2025-11-18
- Live Science, recurso en línea, livescience.com, consulta 2025-12-01
- JSTOR Daily, recurso en línea, daily.jstor.org, consulta 2025-12-17

El acceso no se concede.
Se demuestra.
Únete al Club y recibe antes que nadie los expedientes que el archivo no muestra en la superficie. Historias verificadas, hallazgos improbables y verdades que aún resisten al olvido.
El rigor abre las puertas que la prisa mantiene cerradas.

